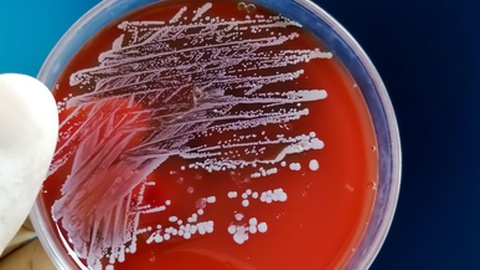
None

Marítimo vence Prémio Assistências da Liga Sabseg
Verde-rubros lideram ranking com um total de 76.580 espectadores no seu estádio

Foto ASPRESS
O Marítimo venceu o Prémio Assistências da Liga Portugal Sabseg, no período compreendido entre as jornadas 17 e 20 da competição, com uma taxa de ocupação de 77,91% nos três jogos disputados na condição de visitado.
O estádio do Marítimo recebeu, neste período, um total de 24.693 espectadores nas partidas com o Académico de Viseu, Nacional e Benfica B, com uma média de 8.231 espectadores.
O Marítimo lidera ainda o ranking absoluto de assistências com um total de 76.580 espectadores que se deslocaram ao estádio em 10 jogos.